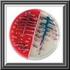
BD BBL CHROMagar Salmonella* / XLD Agar (Biplate)

BD Group B Streptococcus Differential Agar (Granada Medium)
|
|
|
- Charlotte Svendsen
- 9 år siden
- Visninger:
Transkript
1 BRUGSANVISNING PLADEMEDIER KLAR TIL BRUG PA Rev.: Apr TILSIGTET BRUG (gruppe B- streptokokdifferentialagar (Granada-medium)) bruges til isolering og identifikation af Streptococcus agalactiae (gruppe B-Streptococcus) fra kliniske præparater. PROCEDURENS PRINCIPPER OG FORKLARING Mikrobiologisk metode. Streptococcus agalactiae er årsag til svære infektioner hos nyfødte, herunder blodforgiftning, meningitis og infektioner af multiple organer. 1-3 Det nyfødte barn inficeres af moderen, som kan have organismen asymptomatisk i vaginalfloraen. Incidensen er ca. 1,5 pr fødsler af levende børn, og mortaliteten er ca. 8,7 %. 3 Det er vist, at rettidig påvisning af stoffet i vaginalfloraen hos gravide kvinder efterfulgt af relevant behandling af det nyfødte barn kan reducere risikoen for infektion signifikant. 2,3 Standardisoleringsteknikken til isolering fra vaginalpræparater er brug af blodagar eller selektiv blodagar og påvisning af den karakteristiske betahæmolyse, efterfulgt af biokemisk eller serologisk identifikation. 1 Nyere undersøgelser har vist, at også et lavt antal af S. agalactiae i vaginalfloraen kan udgøre en risiko for, at det nyfødte barn inficeres. Derfor er berigelsesteknikker som f.eks. LIM Broth (LIM-bouillon) blevet anbefalet. 4 Dette berigelsesmedium er dog ikke fuldstændigt selektivt for S. agalactiae, og andre grampositive organismer kan ligeledes beriges ved denne metode og eventuelt skjule S. agalactiae. I de senere år er modifikationer af Islam-mediet, der blev beskrevet i 1977, blevet testet for deres egnethed til at påvise og isolere organismen. 5,6 På disse medier ligesom på New Granada-mediet, som er en nylig modifikation af Islam-mediet, producerer betahæmolytiske stammer af S. agalactiae orange til laksefarvede kolonier. 7,8 Farvningen af kolonien skyldes organismens eget pigment, granadaene, en ornithinrhamnopolyen. 16 Pigmenteringen er særdeles specifik og forekommer ikke med andre streptokokker end gruppe B eller med andre organismer. New Granada-mediets stabilitet er dog begrænset. 9,10 er en modifikation af New Granada-mediet med forbedret stabilitet og selektivitet. Proteose pepton nr. 3 en proteinkilde og skaffer de nødvendige forgængere for produktion og vækst af pigment. Stivelse er et næringsstof og agerer som en stabilisator for pigmentet. Glukose, pyruvat og cystein er næringsstoffer. Magnesium er et sporstof. Kombinationen af MOPS og fosfat virker som en phbuffer. Krystalviolet hæmmer stafylokokker. Der er tilsat hæmmere og fremmere for at undertrykke den ledsagende flora, som f.eks. gramnegative bakterier og strengt anaerobe bakterier, og for at styrke pigmentdannelsen. REAGENSER Formel* pr. liter oprenset vand Proteose pepton nr. 3 25,0 g Dinatriumhydrogenfosfat 10,7 g Majsstivelse 14,0 Krystalviolet 0,0005 Glukose 2,5 Hæmmere og fremmere 0,021 Pyrodruesyre natriumsalt 1,0 Agar 15,2 Cysteinhydrochlorid 0,1 Magnesiumsulfat 0,3 MOPS (3-morpholinpropansulfonsyre), 11,0 heminatriumsalt ph 7,4 ± 0,2 * Justeret og/eller suppleret som krævet for at opfylde funktionskriterierne. PA Side 1 af 5
2 FORHOLDSREGLER. Kun til professionel brug. Pladerne må ikke anvendes, hvis de viser tegn på mikrobiel kontaminering, misfarvning, udtørring, brud eller andre tegn på nedbrydning. Læs dokumentet GENEREL BRUGSANVISNING for procedurer om aseptisk håndtering, biologiske farer og bortskaffelse af brugte produkter. OPBEVARING OG HOLDBARHED Pladerne opbevares efter modtagelse i mørke ved 2 8 C i deres originale hylsterindpakning indtil umiddelbart inden ibrugtagning. Undgå nedfrysning og overophedning. Pladerne kan inokuleres indtil udløbsdatoen (se etiketten på pakken) og inkuberes i de anbefalede inkubationstider. Plader fra åbnede stabler med 10 plader kan bruges i en uge, når de opbevares i et rent område ved 2 8 C. BRUGERKVALITETSKONTROL Inokulér repræsentative prøver med følgende stammer (se dokumentet GENEREL BRUGSANVISNING for at få detaljer). Inkubér anaerobt i h ved 35 2 C. Stammer Streptococcus agalactiae ATCC Streptococcus pyogenes ATCC Enterococcus faecalis ATCC Staphylococcus aureus ATCC Bacteroides fragilis ATCC Proteus mirabilis ATCC Ikke-inokuleret Vækstresultater Vækst god til udmærket; orange kolonier af lille eller medium størrelse med eller uden farveløse kanter Vækst; meget små farveløse til grå kolonier Vækst; medium størrelse farveløse til grå kolonier Fuldstændig hæmning Delvis til fuldstændig hæmning Delvis til fuldstændig hæmning, sværmen fuldstændigt hæmmet, farveløse kolonier Hvide til lysegrålige, opakke PROCEDURE Vedlagte materialer (90 mm Stacker plader). Mikrobiologisk kontrolleret. Materialer, der ikke er vedlagt Hjælpekulturmedier, reagenser og laboratorieudstyr som påkrævet. Præparattyper kan bruges til isolering af S. agalactiae (gruppe B-streptokokker) fra alle slags humane, kliniske præparater. Hyppige præparater omfatter podninger fra de kvindelige kønsdele eller podninger og andre præparater fra nyfødte. Anvend egnede teknikker til præparatindsamling og -transport. 1,11 Testprocedure Udstryg præparatet så hurtigt som muligt efter modtagelse i laboratoriet på BD Group B Streptococcus Differential Agar (Granada Medium). Udstrygningspladen anvendes primært til at isolere rene kulturer fra præparater, der indeholder blandet flora. Hvis materialet dyrkes direkte fra en podepind, kan podepinden rulles over et lille område på overfladen ved kanten. Derefter udstryges der for isolation fra dette inokulerede område. Inkubér anaerobt i h ved 35 2 C. Hvis pladerne er negative, kan de inkuberes i yderligere 18 til 24 h, selv om dette normalt ikke er nødvendigt. For at kunne isolere alle patogener, der er involveret i en infektion eller kolonidannelse, skal prøven også udstryges på en blodagarplade, f.eks. BD Columbia Agar with 5% Sheep Blood, som bør inkuberes i en CO 2 -beriget atmosfære i h ved 35 2 C. Hvis flydende forberigelsesmedier som f.eks. LIM-bouillon anvendes, kan de videredyrkes på BD Group B Streptococcus Differential Agar PA Side 2 af 5
3 (Granada Medium) med en løkkefuld af bouillonen efter h inkubation og inkuberes som beskrevet ovenfor. Resultater Efter inkubation producerer betahæmolytiske stammer af S. agalactiae små til mellemstørrelse, blege til stærkt orange eller laksefarvede-orange kolonier, som muligvis kan være omgivet af farveløse kanter. For at kunne påvise svagt pigmenterede stammer skal pladerne aflæses på en hvid overflade. Enhver styrke af orange pigmentering regnes for et positivt resultat. Pladerne må ikke holdes foran en lyskilde under aflæsning! Stafylokokker, gramnegative stave og strengt anaerobe bakterier vil normalt være fuldstændigt hæmmet på mediet. De fleste andre streptokokker og enterokokker vokser uden hæmning, men producerer farveløse til grå kolonier. Ikke-hæmolytiske stammer af S. agalactiae producerer også grå til gråblå kolonier. De forekommer sjældent (op til 4 % hos gravide kvinder). Til at differentiere ikke-hæmolytiske B-streptokokker fra enterokokker eller non-gruppe B- streptokokker kan der udføres en PYR-test (brug BD DrySlide PYR kit, kat. nr ) direkte på grå til blågrå kolonier på : Enterokokker, Streptococcus pyogenes og en række andre streptokokker er PYR-positive (= rød til lilla farve inden for 1 min), hvorimod S. agalactiae og en række andre streptokokker er PYRnegative (= gullige til farveløse). 15 Isolater med PYR-negative resultater fra grå eller gråblå kolonier skal testes yderligere for at bekræfte forekomsten af ikke-hæmolytiske S. agalactiaestammer, f.eks. ved serologisk typebestemmelse. Den orange pigmentering på dette medium er meget specifik for S. agalactiae, og serologisk eller biokemisk identifikation er ikke nødvendig for bekræftelse. Dog kan serologisk typebestemmelse udføres direkte fra BD Group B Streptococcus Differential Agar (Granada Medium) uden yderligere videredyrkning. BBL Streptocard Enzyme Latex Test Kit (Streptocard enzymlatextestkit) (kat. nr ) kan anvendes til dette formål. Desuden skal BD Columbia Agar with 5% Sheep Blood pladen inspiceres for tilstedeværelsen af ikke-hæmolytiske stammer af S. agalactiae og for yderligere patogener. FUNKTIONSDATA OG PROCEDURENS BEGRÆNSNINGER bruges til isolering og identifikation af Streptococcus agalactiae (gruppe B-streptokokker) fra alle slags humane, kliniske præparater. Den orange kolonifarvning på dette medium er yderst specifik for S. agalactiae (se Funktionsdata). Derfor er konfirmatoriske test ikke nødvendige. I tilfælde af tvivl, eller hvor der er svagt pigmenterede stammer, bør serologisk gruppering og/eller en PYR-test udføres direkte fra isoleringspladen. Det er rapporteret, at de gener, der er ansvarlige for pigmentproduktionen og for produktionen af hæmolysin hos S. agalactiae, er genetisk kædet. 12,13 Ca. 1 2 % af S. agalactiae-stammer er ikke-hæmolytiske 14 og bliver derfor måske ikke pigmenteret på BD Group B Streptococcus Differential Agar (Granada Medium). Det er dog blevet bestemt internt, at svage hæmolysinproducenter, der forekommer ikke-hæmolytiske på de fleste blodagarmedier, stadig kan være svage pigmentproducenter. Det er rapporteret, at hæmolysin er en af de vigtigste patogenicitetsfaktorer hos S. agalactiae. 12,13 For at kunne påvise alle de patogener, der er involveret i en infektion, inklusive ikkehæmolytiske stammer af B-streptokokker, skal et blodagarmedium som f.eks. BD Columbia Agar with 5% Sheep Blood også inokuleres med prøven. er ikke egnet til isolering af andre streptokokker end S. agalactiae eller andre patogener, der kan give lignende infektioner (f.eks. Listeria monocytogenes). Dette mediums funktion med veterinærpræparater er ikke blevet bestemt. Funktionsdata Der blev foretaget en funktionsevaluering med 151 kliniske præparater (vaginal- og cervikalpodninger, forskellige præparater fra nyfødte), der var påvist positive for S. agalactiae, ved standardpladedyrkning på en blodagarplade efterfulgt af serologisk typebestemmelse af PA Side 3 af 5
4 isolaterne. 15 Af disse 151 præparater var 148 positive ved anden dyrkning på BD Columbia Agar with 5% Sheep Blood og gav ét ikke-hæmolytisk og 147 betahæmolytiske isolater. Efter anaerob inkubation i h på BD Group B Streptococcus Differential Agar (Granada Medium) gav 149 af de 151 præparater vækst af B-streptokokker. Af disse gav 148 vilkårlige typer orange af kolonier (sensitivitet 98 %), som alle blev identificeret serologisk som værende B-streptokokker. Af disse 148 kulturer fik tre score som meget blegorange. Hvis disse tre kulturer trækkes fra, opnås 96 % sensitivitet. I denne undersøgelse blev inokulerede plader af BD Group B Streptococcus Differential Agar (Granada Medium) også inkuberet i en aerob atmosfære beriget med kuldioxid. Under disse inkubationsforhold var sensitiviteten 96,8 %. På disse plader fik 14 kulturer score som meget blegorange. Hvis disse trækkes fra, er sensitiviteten 87,4 %. Ved anaerob inkubation blev der opnået mange flere isolater med en stærk orange kolonifarvning end efter inkubationen i en aerob atmosfære beriget med kuldioxid (P < 0,005). Desuden var kolonier af mange stammer større, når de blev inkuberet anaerobt. Derfor forbedrer den anaerobe inkubation påvisningen af orangefarvede kolonier signifikant. I denne evaluering blev 52 præparater, der tidligere var blevet påvist negative for S. agalactiae, også inkluderet. Der opnåedes ingen falsk positive ved dyrkning på BD Group B Streptococcus Differential Agar (Granada Medium) (specificitet = 100 %). Brug af forbedrer og fremskynder diagnosen af B-streptokokker og reducerer omkostningerne og tiden, da yderligere identifikationstest fra orange kolonier er unødvendige. LITTERATUR 1. Ruoff, K.L., R.A. Whiley, and D. Beighton. Streptococcus. In: Murray, P. R., E. J. Baron, J.H. Jorgensen, M. A. Pfaller, and R. H. Yolken (ed.). Manual of clinical microbiology, 8 th ed. American Society for Microbiology, Washington, D.C. 2. Schuchat, A Epidemiology of group B streptococcal disease in the United States. Clin. Microbiol. Rev. 11: Juncosa, T., et al Infeción neonatal por Streptococcus agalactiae. Estudio multicéntrico en el área de Barcelona. Enferm. Infecc. Microbiol. Clin. 16: Centers for Disease Control and Prevention Prevention of perinatal group B streptococcal diaease: a public health perspective. Morbid. Mortal. Weekly Rep. 45: Islam, A.K.M Rapid recognition of group B streptococci. Lancet I: de la Rosa, M., et al Granada medium for detection and identification of group B streptococci. J. Clin. Microbiol. 18: de la Rosa, M., et al New Granada medium for detection and identification of group B streptococci. J. Clin. Microbiol. 30: Reardon, E.P., et al Evaluation of a rapid method for the detection of vaginal group B streptococci in women in labor. Am. J. Obstet. Gynecol. 184: Overman, S.B., et al Evaluation of methods to increase the sensitivity and timeliness of detection of Streptococcus agalactiae in pregnant women. J. Clin. Microbiol. 40: de la Rosa-Fraile, M Granada agar sensitivity and detection of group B Streptococcus. Letter to the Editor. J. Clin. Microbiol. 41: Thomson, R.B., and J.M. Miller Specimen collection, transport, and processing: bacteriology. In: Murray, P. R., E. J. Baron, J.H. Jorgensen, M. A. Pfaller, and R. H. Yolken (ed.). Manual of clinical microbiology, 8th ed. American Society for Microbiology, Washington, D.C. 12. Spellerberg, B., et al Identification of genetic determinants for the hemolytic activity of Streptococcus agalactiae by ISS1 transposition. J. Bacteriol. 181: Pritzlaff, C.A., et al Genetic basis for the ß-haemolytic/cytolytic activity of group B Streptococcus. Molec. Microbiol. 39: Edwards, M. and J. Baker Streptococcus agalactiae. In: Mandell, G.I., et al. (eds.) Principles and practice of infectious diseases. New York Medical Publications, New York, p Data i arkiv. 2003; BD Diagnostic Systems Europe. Heidelberg, Tyskland. 16. Rosa-Fraile, M., et al Granadaene: proposed structure of the Group B Streptococcus polyenic pigment. Apppl. Environm. Microbiol. 72: PA Side 4 af 5
5 EMBALLERING/BESTILLING REF Plademedier klar til brug, 20 plader YDERLIGERE OPLYSNINGER Kontakt den lokale BD-repræsentant angående yderligere oplysninger. Becton Dickinson GmbH Tullastrasse 8 12 D Heidelberg/Germany Phone: Fax: [email protected] ATCC is a trademark of the American Type Culture Collection BD, BD Logo and all other trademarks are property of Becton, Dickinson and Company BD PA Side 5 af 5
BD Columbia CNA Agar with 5% Sheep Blood, Improved II
 PA-257303.04 Side 1 af 5 BRUGSANVISNING KLAR TIL BRUG PLADEMEDIER PA-257303.04 Rev.: Sep 2011 TILSIGTET BRUG (BD Columbia CNA agar med 5% fåreblod, forbedret) er et selektivt medium, som anvendes til isolering
PA-257303.04 Side 1 af 5 BRUGSANVISNING KLAR TIL BRUG PLADEMEDIER PA-257303.04 Rev.: Sep 2011 TILSIGTET BRUG (BD Columbia CNA agar med 5% fåreblod, forbedret) er et selektivt medium, som anvendes til isolering
BD Chocolate Agar (GC II Agar with IsoVitaleX) BD Chocolate Agar (Blood Agar No. 2 Base)
 BRUGSANVISNING PLADEMEDIER KLAR TIL BRUG PA-254060.06 Rev.: Sep 2011 BD Chocolate Agar (GC II Agar with IsoVitaleX) TILSIGTET BRUG BD Chocolate Agar (GC II Agar with IsoVitaleX) og BD Chocolate Agar (Blood
BRUGSANVISNING PLADEMEDIER KLAR TIL BRUG PA-254060.06 Rev.: Sep 2011 BD Chocolate Agar (GC II Agar with IsoVitaleX) TILSIGTET BRUG BD Chocolate Agar (GC II Agar with IsoVitaleX) og BD Chocolate Agar (Blood
BD MacConkey II Agar / Columbia CNA Agar Improved II with 5% Sheep Blood (Biplate)
 BRUGSANVISNING PLADEMEDIER KLAR TIL BRUG PA-257574.02 Rev.: Sept. 2015 BD MacConkey II Agar / Columbia CNA Agar Improved II with 5% Sheep Blood (Biplate) TILSIGTET BRUG BD MacConkey II Agar / Columbia
BRUGSANVISNING PLADEMEDIER KLAR TIL BRUG PA-257574.02 Rev.: Sept. 2015 BD MacConkey II Agar / Columbia CNA Agar Improved II with 5% Sheep Blood (Biplate) TILSIGTET BRUG BD MacConkey II Agar / Columbia
BD CLED Agar / MacConkey II Agar (Biplate)
 BRUGSANVISNING PLADEMEDIER KLAR TIL BRUG PA-257562.01 Rev.: Jan. 2016 BD CLED Agar / MacConkey II Agar (Biplate) TILSIGTET BRUG BD CLED Agar / MacConkey II Agar (Biplate) anvendes til mikrobiologisk urinanalyse.
BRUGSANVISNING PLADEMEDIER KLAR TIL BRUG PA-257562.01 Rev.: Jan. 2016 BD CLED Agar / MacConkey II Agar (Biplate) TILSIGTET BRUG BD CLED Agar / MacConkey II Agar (Biplate) anvendes til mikrobiologisk urinanalyse.
BD BBL TM CHROMagar TM CPE
 BRUGSANVISNING PLADEMEDIUM KLAR TIL BRUG BD BBL TM CHROMagar TM CPE PA-257681.02 Rev.: Januar 2017 TILSIGTET BRUG BD BBL CHROMagar CPE er et selektivt chromogent screeningmedium til påvisning af carbapenemase-producerende
BRUGSANVISNING PLADEMEDIUM KLAR TIL BRUG BD BBL TM CHROMagar TM CPE PA-257681.02 Rev.: Januar 2017 TILSIGTET BRUG BD BBL CHROMagar CPE er et selektivt chromogent screeningmedium til påvisning af carbapenemase-producerende
BD BBL CHROMagar ESBL (Biplate)
 BRUGSANVISNING PLADEMEDIER KLAR TIL BRUG PA-257606.02 Rev.: januar 2016 BD BBL CHROMagar ESBL (Biplate) TILSIGTET BRUG BBL CHROMagar ESBL (Biplate) er et selektivt chromogent screeningmedium til isolering
BRUGSANVISNING PLADEMEDIER KLAR TIL BRUG PA-257606.02 Rev.: januar 2016 BD BBL CHROMagar ESBL (Biplate) TILSIGTET BRUG BBL CHROMagar ESBL (Biplate) er et selektivt chromogent screeningmedium til isolering
BD Sabouraud Glucose Agar
 BRUGSANVISNING DELVIS FÆRDIGE FLASKEMEDIER BA-257104.01 Rev.: August 2003 BD Sabouraud Glucose Agar TILSIGTET BRUG BD Sabouraud Glucose Agar (glukoseagar), der leveres i flasker, er et delvis færdigt medium,
BRUGSANVISNING DELVIS FÆRDIGE FLASKEMEDIER BA-257104.01 Rev.: August 2003 BD Sabouraud Glucose Agar TILSIGTET BRUG BD Sabouraud Glucose Agar (glukoseagar), der leveres i flasker, er et delvis færdigt medium,
BD CHROMagar Orientation Medium
 BRUGSANVISNING PLADEMEDIER KLAR TIL BRUG PA-257481.03 Rev.: Sep 2011 BD CHROMagar Orientation Medium TILSIGTET BRUG BD CHROMagar Orientation Medium (orienteringsmedium) er et non-selektivt medium til isolering,
BRUGSANVISNING PLADEMEDIER KLAR TIL BRUG PA-257481.03 Rev.: Sep 2011 BD CHROMagar Orientation Medium TILSIGTET BRUG BD CHROMagar Orientation Medium (orienteringsmedium) er et non-selektivt medium til isolering,
PROCEDURENS PRINCIPPER
 GasPak EZ gasudviklende beholdersystemer 8010412/04 2007/09 Dansk TILSIGTET BRUG GasPak EZ gasudviklende beholdersystemer er flerbrugssystemer, som producerer atmosfærer egnet til understøttelse af primær
GasPak EZ gasudviklende beholdersystemer 8010412/04 2007/09 Dansk TILSIGTET BRUG GasPak EZ gasudviklende beholdersystemer er flerbrugssystemer, som producerer atmosfærer egnet til understøttelse af primær
BD BBL CHROMagar 0157
 BRUGSANVISNING PLADEMEDIER KLAR TIL BRUG PA241.4 Rev.: Dec 28 Amerikansk patentnr. 6,16,743 BD BBL CHROMagar 17 TILSIGTET BRUG BBL CHROMagar O17 er et selektivt medium til isolering, differentiering og
BRUGSANVISNING PLADEMEDIER KLAR TIL BRUG PA241.4 Rev.: Dec 28 Amerikansk patentnr. 6,16,743 BD BBL CHROMagar 17 TILSIGTET BRUG BBL CHROMagar O17 er et selektivt medium til isolering, differentiering og
BBL CHROMagar MRSAII*
 BRUGSANVISNING PLADEMEDIER KLAR TIL BRUG BBL CHROMagar MRSAII* PA-257434.01 Rev.:18 Juni 08 TILSIGTET BRUG BBL CHROMagar MRSAII (CMRSAII) er et selektivt og differentielt medium til direkte påvisning af
BRUGSANVISNING PLADEMEDIER KLAR TIL BRUG BBL CHROMagar MRSAII* PA-257434.01 Rev.:18 Juni 08 TILSIGTET BRUG BBL CHROMagar MRSAII (CMRSAII) er et selektivt og differentielt medium til direkte påvisning af
BD BBL CHROMagar MRSA*
 PA-257308.01 Side 1 af 9 BRUGSANVISNING PLADEMEDIER KLAR TIL BRUG PA-257308.01 Rev.: Dec 2005 BD BBL CHROMagar MRSA* TILSIGTET BRUG BBL CHROMagar MRSA er et selektivt og differentielt medium til direkte
PA-257308.01 Side 1 af 9 BRUGSANVISNING PLADEMEDIER KLAR TIL BRUG PA-257308.01 Rev.: Dec 2005 BD BBL CHROMagar MRSA* TILSIGTET BRUG BBL CHROMagar MRSA er et selektivt og differentielt medium til direkte
BD Mueller Hinton II Agar BD Mueller Hinton II Agar 150 mm BD Mueller Hinton II Agar, Square
 BRUGSANVISNING PLADEMEDIER KLAR TIL BRUG PA-254032.07 Rev.: April 2013 BD Mueller Hinton II Agar BD Mueller Hinton II Agar 150 mm BD Mueller Hinton II Agar, Square TILSIGTET BRUG BD Mueller Hinton II Agar,
BRUGSANVISNING PLADEMEDIER KLAR TIL BRUG PA-254032.07 Rev.: April 2013 BD Mueller Hinton II Agar BD Mueller Hinton II Agar 150 mm BD Mueller Hinton II Agar, Square TILSIGTET BRUG BD Mueller Hinton II Agar,
FLEXICULT PRODUKTINFORMATION S T A T E N S S E R U M I N S T I T U T. forebygger og bekæmper smitsomme sygdomme og medfødte lidelser
 FLEXICULT SSI-urinkit S T A T E N S S E R U M I N S T I T U T forebygger og bekæmper smitsomme sygdomme og medfødte lidelser Statens Serum Institut Artillerivej 5 2300 København S Tlf.: 3268 3268 Fax:
FLEXICULT SSI-urinkit S T A T E N S S E R U M I N S T I T U T forebygger og bekæmper smitsomme sygdomme og medfødte lidelser Statens Serum Institut Artillerivej 5 2300 København S Tlf.: 3268 3268 Fax:
FLEXICULT SSI-URINKIT
 FLEXICULT SSI-URINKIT Udarbejdet af Niels Frimodt-Møller, Overlæge dr.med. Aase Meyer, Produktspecialist Layout Anja Bjarnum 2 FLEXICULT SSI-URINKIT er et dyrkningskit til diagnosticering af urinvejsinfektioner
FLEXICULT SSI-URINKIT Udarbejdet af Niels Frimodt-Møller, Overlæge dr.med. Aase Meyer, Produktspecialist Layout Anja Bjarnum 2 FLEXICULT SSI-URINKIT er et dyrkningskit til diagnosticering af urinvejsinfektioner
Gram Stain Kits and Reagents
 Gram Stain Kits and Reagents 8820191JAA 2008/06 Dansk Gram Stain Kit 1 Kat. nr. 212539 Gram Crystal Violet Til differentialfarvning af bakterier. Gram Iodine (stabiliseret) Gram Stain Kit 1 212524 Gram
Gram Stain Kits and Reagents 8820191JAA 2008/06 Dansk Gram Stain Kit 1 Kat. nr. 212539 Gram Crystal Violet Til differentialfarvning af bakterier. Gram Iodine (stabiliseret) Gram Stain Kit 1 212524 Gram
BD Mueller Hinton Agar with 5% Sheep Blood BD Mueller Hinton Agar with 5% Sheep Blood (150 mm) BD Mueller Hinton Agar with 5% Sheep Blood, Square
 BRUGSANVISNING PLADEMEDIER KLAR TIL BRUG PA-254030.07 Rev.: April 2013 BD Mueller Hinton Agar with 5% Sheep Blood BD Mueller Hinton Agar with 5% Sheep Blood (150 mm) BD Mueller Hinton Agar with 5% Sheep
BRUGSANVISNING PLADEMEDIER KLAR TIL BRUG PA-254030.07 Rev.: April 2013 BD Mueller Hinton Agar with 5% Sheep Blood BD Mueller Hinton Agar with 5% Sheep Blood (150 mm) BD Mueller Hinton Agar with 5% Sheep
Evaluering af to forskellige screeningsmetoder til detektion af Streptococcus agalactiae hos gravide
 2014 Evaluering af to forskellige screeningsmetoder til detektion af Streptococcus agalactiae hos gravide Evaluation of two different screening methods for the detection of Streptococcus agalactiae in
2014 Evaluering af to forskellige screeningsmetoder til detektion af Streptococcus agalactiae hos gravide Evaluation of two different screening methods for the detection of Streptococcus agalactiae in
BD BBL CHROMagar Salmonella* / XLD Agar (Biplate)
BRUGSANVISNING PLADEMEDIER KLAR TIL BRUG PA-257372.02 Rev.: Mar 2013 BD BBL CHROMagar Salmonella* / XLD Agar (Biplate) * U.S. patent nr. 5,098,832, 5,194,374 TILSIGTET BRUG BBL CHROMagar Salmonella er
BRUGSANVISNING PLADEMEDIER KLAR TIL BRUG PA-257372.02 Rev.: Mar 2013 BD BBL CHROMagar Salmonella* / XLD Agar (Biplate) * U.S. patent nr. 5,098,832, 5,194,374 TILSIGTET BRUG BBL CHROMagar Salmonella er
BBL CHROMagar MRSA II*
 BRUGSANVISNING PLADEMEDIER KLAR TIL BRUG PA-257434.03 Rev.: March 2012 BBL CHROMagar MRSA II* TILSIGTET BRUG BBL CHROMagar MRSA II (CMRSAII) er et selektivt og differentielt medium til direkte, kvalitativ
BRUGSANVISNING PLADEMEDIER KLAR TIL BRUG PA-257434.03 Rev.: March 2012 BBL CHROMagar MRSA II* TILSIGTET BRUG BBL CHROMagar MRSA II (CMRSAII) er et selektivt og differentielt medium til direkte, kvalitativ
Identifikation af Candida species på kromogene medier
 Bioanalytikerstuderende Majbritt Bach Rasmussen 2013 Identifikation af Candida species på kromogene medier Studienummer: 15 19 16 I vejleder: Birte Sivebæk Lektor Cand. Scient. K vejleder: Dorte Paulmann
Bioanalytikerstuderende Majbritt Bach Rasmussen 2013 Identifikation af Candida species på kromogene medier Studienummer: 15 19 16 I vejleder: Birte Sivebæk Lektor Cand. Scient. K vejleder: Dorte Paulmann
6.6. Substratoversigt
 substrater geblomme, antibiotika m.v.. l) Ophældning på plader, 8-15 ml pr. plade. m) Eventuel tørring af plader. n) Plader, der ikke bruges med det samme, kan gemmes i køleskab, indpakket i plastposer.
substrater geblomme, antibiotika m.v.. l) Ophældning på plader, 8-15 ml pr. plade. m) Eventuel tørring af plader. n) Plader, der ikke bruges med det samme, kan gemmes i køleskab, indpakket i plastposer.
Petrifilm Type EB til bestemmelse af Enterobacteriaceae
 Aflæsningsguide og brugsvejledning Petrifilm Type EB til bestemmelse af Enterobacteriaceae 1 2 1 2 Enterobacteriaceae CFU = 1 Det er let at tælle Enterobacteriaceae kolonier på Petrifilm EB plader. Alle
Aflæsningsguide og brugsvejledning Petrifilm Type EB til bestemmelse af Enterobacteriaceae 1 2 1 2 Enterobacteriaceae CFU = 1 Det er let at tælle Enterobacteriaceae kolonier på Petrifilm EB plader. Alle
Aptima Multitest Swab Specimen Collection Kit
 Multitest Swab Specimen Collection Kit Aptima Tilsigtet anvendelse Aptima Multitest Swab Specimen Collection Kit (Aptima Multitest prøvetagningskit til podning) er til brug med Aptima assays. Aptima Multitest
Multitest Swab Specimen Collection Kit Aptima Tilsigtet anvendelse Aptima Multitest Swab Specimen Collection Kit (Aptima Multitest prøvetagningskit til podning) er til brug med Aptima assays. Aptima Multitest
BD BBL Mycoslide. BRUGSANVISNING KLAR TIL BRUG DYPPEOBJEKTGLASMEDIER DA-273157.00 Rev.: Juni 2003
 DA-273157.00-1 - BRUGSANVISNING KLAR TIL BRUG DYPPEOBJEKTGLASMEDIER DA-273157.00 Rev.: Juni 2003 BD BBL Mycoslide TILSIGTET BRUG BBL Mycoslide er et treside dyppeobjektglas, der indeholder medier til påvisning
DA-273157.00-1 - BRUGSANVISNING KLAR TIL BRUG DYPPEOBJEKTGLASMEDIER DA-273157.00 Rev.: Juni 2003 BD BBL Mycoslide TILSIGTET BRUG BBL Mycoslide er et treside dyppeobjektglas, der indeholder medier til påvisning
Opformeringsmedie til identifikation af MRSA
 Opformeringsmedie til identifikation af MRSA Contrast MRSA broth fra Oxoid versus ChromID MRSA fra Biomerieux Forfatter: Sofie Skov Frost (60080212) Fødselsdato: 24/7 1988 Periode for bachelorprojekt:
Opformeringsmedie til identifikation af MRSA Contrast MRSA broth fra Oxoid versus ChromID MRSA fra Biomerieux Forfatter: Sofie Skov Frost (60080212) Fødselsdato: 24/7 1988 Periode for bachelorprojekt:
VIGTIG INFO OM PRODUKT KORREKTION FCSA 2752 API ZYM B x2 (Ref )
 biomérieux NORDICS Customer Service Department Direct no.: +46 31 68 58 58 Fax no.: +46 31 68 48 68 e-mail: [email protected] Our Ref.: FSCA 2752 IMPORTANT: URGENT FIELD SAFETY NOTICE
biomérieux NORDICS Customer Service Department Direct no.: +46 31 68 58 58 Fax no.: +46 31 68 48 68 e-mail: [email protected] Our Ref.: FSCA 2752 IMPORTANT: URGENT FIELD SAFETY NOTICE
BACTEC MGIT 960 SIRE Kits
 BACTEC MGIT 960 SIRE Kits Til antimycobakteriel følsomhedsundersøgelse af Mycobacterium tuberculosis 8008200 2007/03 Dansk TILSIGTET BRUG BACTEC MGIT 960 SIRE Kit er en hurtig, kvalitativ procedure til
BACTEC MGIT 960 SIRE Kits Til antimycobakteriel følsomhedsundersøgelse af Mycobacterium tuberculosis 8008200 2007/03 Dansk TILSIGTET BRUG BACTEC MGIT 960 SIRE Kit er en hurtig, kvalitativ procedure til
FLEXICULT VET URINTEST. SSI Diagnostica
 FLEXICULT VET URINTEST SSI Diagnostica Udarbejdet af Tanja Rasmussen, Dyrlæge Mette Kerrn, Cand.Pharm., PhD Aase Meyer, produktspecialist Layout Anja Bjarnum/Kristian Teilmann Frederiksen 2 Flexicult Vet
FLEXICULT VET URINTEST SSI Diagnostica Udarbejdet af Tanja Rasmussen, Dyrlæge Mette Kerrn, Cand.Pharm., PhD Aase Meyer, produktspecialist Layout Anja Bjarnum/Kristian Teilmann Frederiksen 2 Flexicult Vet
F22 Bakterier struktur og funktion
 F22 Bakterier struktur og funktion Uffe B. Skov Sørensen INSTITUT FOR BIOMEDICIN Dias 1 Disposition Forskelle mellem bakterier og vore egne celler Hvad er en bakterie? Dyrkning, farvning og identifikation
F22 Bakterier struktur og funktion Uffe B. Skov Sørensen INSTITUT FOR BIOMEDICIN Dias 1 Disposition Forskelle mellem bakterier og vore egne celler Hvad er en bakterie? Dyrkning, farvning og identifikation
Petrifilm. Environmental Listeria Plade. Aflæsningsguide
 Aflæsningsguide Petrifilm Environmental Listeria Plade Denne guide viser eksempler på de forskellige aflæsningsresultater, der kan opnås med M Petrifilm Environmental Listeria Plader. For yderligere oplysninger
Aflæsningsguide Petrifilm Environmental Listeria Plade Denne guide viser eksempler på de forskellige aflæsningsresultater, der kan opnås med M Petrifilm Environmental Listeria Plader. For yderligere oplysninger
BIOLOGISKE INDIKATORER
 BIOLOGISKE INDIKATORER BIOLOGISKE INDIKATORER Biologiske indikatorer (BI) leveret fra SSI Diagnostica er udviklet til mikrobiologisk kontrol og validering af sterilisationsprocesser og er fremstillet i
BIOLOGISKE INDIKATORER BIOLOGISKE INDIKATORER Biologiske indikatorer (BI) leveret fra SSI Diagnostica er udviklet til mikrobiologisk kontrol og validering af sterilisationsprocesser og er fremstillet i
BD Mueller Hinton Fastidious Agar (MH-F)
 BRUGSANVISNING PLADEMEDIER KLAR TIL BRUG PA-257491.01 Rev.: August 2016 BD Mueller Hinton Fastidious Agar (MH-F) TILSIGTET BRUG BD Mueller Hinton Fastidious Agar (MH-F) bruges til test af antimikrobiel
BRUGSANVISNING PLADEMEDIER KLAR TIL BRUG PA-257491.01 Rev.: August 2016 BD Mueller Hinton Fastidious Agar (MH-F) TILSIGTET BRUG BD Mueller Hinton Fastidious Agar (MH-F) bruges til test af antimikrobiel
Diagnosticering af Clostridium perfringens type C infektion i neonatale grise
 Diagnosticering af Clostridium perfringens type C infektion i neonatale grise med real-time PCR og ELISA DVHS 3. maj 2013 Speciale af cand.med.vet. Camilla Bjørn Olesen 1 De næste 25 min Baggrund Formål
Diagnosticering af Clostridium perfringens type C infektion i neonatale grise med real-time PCR og ELISA DVHS 3. maj 2013 Speciale af cand.med.vet. Camilla Bjørn Olesen 1 De næste 25 min Baggrund Formål
BRUGSANVISNING TILSIGTET BRUG SAMMENFATNING OG FORKLARING PRINCIP SAMMENSÆTNING
 BRUGSANVISNING TILSIGTET BRUG LYFO DISK, KWIK-STIK og KWIK-STIK Plus mikroorganismer er beregnet til at blive brugt som kontrol til at verificere performance af analyser, reagenser eller medier, der er
BRUGSANVISNING TILSIGTET BRUG LYFO DISK, KWIK-STIK og KWIK-STIK Plus mikroorganismer er beregnet til at blive brugt som kontrol til at verificere performance af analyser, reagenser eller medier, der er
Studiepraktik Vejledninger til Laboratoriearbejdet i mikrobiologi E 2013/BIS
 Studiepraktik Vejledninger til Laboratoriearbejdet i mikrobiologi E 2013/BIS 1 Makroskopisk og mikroskopisk undersøgelse af bakterier Formål: At udføre makroskopiske og mikroskopiske bakterieundersøgelser.
Studiepraktik Vejledninger til Laboratoriearbejdet i mikrobiologi E 2013/BIS 1 Makroskopisk og mikroskopisk undersøgelse af bakterier Formål: At udføre makroskopiske og mikroskopiske bakterieundersøgelser.
Universal Viral Transport 45 2008/10
 Universal Viral Transport 45 2008/10 0086 Dansk TILSIGTET BRUG BD Universal Viral Transport System (BD universelt virustransportsystem) er beregnet til opsamling og transport af kliniske præparater, der
Universal Viral Transport 45 2008/10 0086 Dansk TILSIGTET BRUG BD Universal Viral Transport System (BD universelt virustransportsystem) er beregnet til opsamling og transport af kliniske præparater, der
Urinundersøgelser i almen praksis stix - dyrkning - resistens
 Mikrobiologi i LKO Urinundersøgelser i almen praksis stix - dyrkning - resistens Bente Gahrn-Hansen og Pia Steinicke Urinvejsinfektioner Urinrørsirritation (urethritis) Akut blærebetændelse (cystitis)
Mikrobiologi i LKO Urinundersøgelser i almen praksis stix - dyrkning - resistens Bente Gahrn-Hansen og Pia Steinicke Urinvejsinfektioner Urinrørsirritation (urethritis) Akut blærebetændelse (cystitis)
Ringtest for identifikation og resistensbestemmelse af mastitispatogener 2014
 Ringtest for identifikation og resistensbestemmelse af mastitispatogener 2014 Ringtest for identifikation og resistensbestemmelse af mastitispatogener 2014 Lina Cavaco Bjørn Lorenzen Jacob Dyring Jensen
Ringtest for identifikation og resistensbestemmelse af mastitispatogener 2014 Ringtest for identifikation og resistensbestemmelse af mastitispatogener 2014 Lina Cavaco Bjørn Lorenzen Jacob Dyring Jensen
Påvisning av methicillinresistens i Stafylokokker. Truls Leegaard NordicAST workshop Göteborg 27. mai
 Påvisning av methicillinresistens i Stafylokokker Truls Leegaard NordicAST workshop Göteborg 27. mai Bakgrunn Methicillin/oxacillin resistente stafylokokker, både Staphylococcus aureus (MRSA) og koagulase
Påvisning av methicillinresistens i Stafylokokker Truls Leegaard NordicAST workshop Göteborg 27. mai Bakgrunn Methicillin/oxacillin resistente stafylokokker, både Staphylococcus aureus (MRSA) og koagulase
Aptima prøvetagningskit til multitestpodning
 Tilsigtet brug Aptima prøvetagningskit til multitestpodning er til brug med Aptima assays. Aptima prøvetagningskit til multitestpodning er beregnet til vaginale podningsprøver taget af klinikeren eller
Tilsigtet brug Aptima prøvetagningskit til multitestpodning er til brug med Aptima assays. Aptima prøvetagningskit til multitestpodning er beregnet til vaginale podningsprøver taget af klinikeren eller
Steen Hoffmann, SSI Jordemoderforeningen, den 8. januar 2015
 SSI, Neonatal konjunktivit forårsaget af gonokokker eller Chlamydia trachomatis Steen Hoffmann Afd. for Mikrobiologi og Infektionskontrol, Statens Serum Institut Conjunctivitis neonatorum Purulent konjunktivit
SSI, Neonatal konjunktivit forårsaget af gonokokker eller Chlamydia trachomatis Steen Hoffmann Afd. for Mikrobiologi og Infektionskontrol, Statens Serum Institut Conjunctivitis neonatorum Purulent konjunktivit
Ringtesten for identifikation og resistensbestemmelse af mastitispatogener 2011
 Ringtesten for identifikation og resistensbestemmelse af mastitispatogener 2011 Ringtesten for identifikation og resistensbestemmelse af mastitispatogener 2011 Rene S. Hendriksen Lars Kunstmann Jacob Dyring
Ringtesten for identifikation og resistensbestemmelse af mastitispatogener 2011 Ringtesten for identifikation og resistensbestemmelse af mastitispatogener 2011 Rene S. Hendriksen Lars Kunstmann Jacob Dyring
Bærerskab, patienten som smittekilde!
 Bærerskab, patienten som smittekilde! Konference med fokus på Infektionshygiejne Region Syddanmark 17. marts 2016, 9:40 10:15 Jens Kjølseth Møller Overlæge, professor dr.med. Klinisk Mikrobiologisk Afdeling
Bærerskab, patienten som smittekilde! Konference med fokus på Infektionshygiejne Region Syddanmark 17. marts 2016, 9:40 10:15 Jens Kjølseth Møller Overlæge, professor dr.med. Klinisk Mikrobiologisk Afdeling
Ringtesten for identifikation og resistensbestemmelse af mastitispatogener 2009
 Ringtesten for identifikation og resistensbestemmelse af mastitispatogener 2009 Ringtesten for identifikation og resistensbestemmelse af mastitispatogener 2009 Rene S. Hendriksen Susanne Karlsmose Frank
Ringtesten for identifikation og resistensbestemmelse af mastitispatogener 2009 Ringtesten for identifikation og resistensbestemmelse af mastitispatogener 2009 Rene S. Hendriksen Susanne Karlsmose Frank
Lely Caring. - fokus på pattespray. innovators in agriculture. www.lely.com
 Lely Caring - fokus på pattespray www.lely.com innovators in agriculture LELY CARING INTRO TIL YVERPLEJE Det er vigtigt med sunde yvere som basis for en optimal mælkeproduktion. I gennemsnit lider én ud
Lely Caring - fokus på pattespray www.lely.com innovators in agriculture LELY CARING INTRO TIL YVERPLEJE Det er vigtigt med sunde yvere som basis for en optimal mælkeproduktion. I gennemsnit lider én ud
Validering af gramfarvning af bakterier
 Valideringsrapport Gramfarvning af bakterier Formålet med valideringen At dokumentere at KMA, OUHs kan anvende gramfarvning til at identificere grampositive og negative bakterier, samt karakterisere morfologi/lejring.
Valideringsrapport Gramfarvning af bakterier Formålet med valideringen At dokumentere at KMA, OUHs kan anvende gramfarvning til at identificere grampositive og negative bakterier, samt karakterisere morfologi/lejring.
Dobbeltfarvning med p16/ki-67 (CINtec PLUS) på cervixcytologiske prøver med low grade of intraepithelial lesion (LSIL)
 Dobbeltfarvning med p16/ki-67 (CINtec PLUS) på cervixcytologiske prøver med low grade of intraepithelial lesion (LSIL) Cytologisk årsmøde 2-3 marts 2012, Odense Marianne Waldstrøm Specialechef, ledende
Dobbeltfarvning med p16/ki-67 (CINtec PLUS) på cervixcytologiske prøver med low grade of intraepithelial lesion (LSIL) Cytologisk årsmøde 2-3 marts 2012, Odense Marianne Waldstrøm Specialechef, ledende
Urinmikroskopi i almen praksis
 Urinmikroskopi i almen praksis Charlotte N. Agergaard og Flemming Schønning Rosenvinge Læger KMA, OUH Dorthe Eva T. Hansen Bioanalytikerunderviser KBF, OUH Akut ukompliceret bakteriel cystitis Bakteriuri
Urinmikroskopi i almen praksis Charlotte N. Agergaard og Flemming Schønning Rosenvinge Læger KMA, OUH Dorthe Eva T. Hansen Bioanalytikerunderviser KBF, OUH Akut ukompliceret bakteriel cystitis Bakteriuri
PCR en test for mastitisbakterier via ydelseskontrolprøver
 Fra dyrkning Til teknologi PCR en test for mastitisbakterier via ydelseskontrolprøver Tema 11 Få maks. ud af din højteknologi Dansk Kvæg Kongres 24 februar 2009 Jørgen Katholm, Mejeriforeningen Side 1
Fra dyrkning Til teknologi PCR en test for mastitisbakterier via ydelseskontrolprøver Tema 11 Få maks. ud af din højteknologi Dansk Kvæg Kongres 24 februar 2009 Jørgen Katholm, Mejeriforeningen Side 1
Undersøgelse af contrast MRSA bouillon til hurtigere identifikation af MRSA
 Undersøgelse af contrast MRSA bouillon til hurtigere identifikation af MRSA 29-05-2013 Forfatter: Sabrina L. L. Christensen (122027) Klinisk vejleder: Bioanalytikeruderviser Erica Bracher Jørgensen Intern
Undersøgelse af contrast MRSA bouillon til hurtigere identifikation af MRSA 29-05-2013 Forfatter: Sabrina L. L. Christensen (122027) Klinisk vejleder: Bioanalytikeruderviser Erica Bracher Jørgensen Intern
PCR en test for mastitisbakterier via ydelseskontrolprøver
 Fra dyrkning Til teknologi PCR en test for mastitisbakterier via ydelseskontrolprøver Tema 11 Få maks. ud af din højteknologi Dansk Kvæg Kongres 24. februar 2009 Jørgen Katholm, Mejeriforeningen Side 1
Fra dyrkning Til teknologi PCR en test for mastitisbakterier via ydelseskontrolprøver Tema 11 Få maks. ud af din højteknologi Dansk Kvæg Kongres 24. februar 2009 Jørgen Katholm, Mejeriforeningen Side 1
ON-FARM DYRKNING MANUAL
 ON-FARM DYRKNING MANUAL Version 1.0 INTRODUKTION On-Farm Dyrkning er et beslutningsstøtteværktøj, der, sammen med information i DMS Dyreregistrering, CMT-test og vejledning fra besætningsdyrlægen samt
ON-FARM DYRKNING MANUAL Version 1.0 INTRODUKTION On-Farm Dyrkning er et beslutningsstøtteværktøj, der, sammen med information i DMS Dyreregistrering, CMT-test og vejledning fra besætningsdyrlægen samt
MRSA. Status, smittemåder og. Robert Skov, overlæge. Statens Serum Institut
 MRSA Status, smittemåder og begrænsning af smitte Robert Skov, overlæge Statens Serum Institut MRSA MRSA er S. aureus, der er resistente = modstandsdygtige overfor alle antibiotika i penicillinfamilien
MRSA Status, smittemåder og begrænsning af smitte Robert Skov, overlæge Statens Serum Institut MRSA MRSA er S. aureus, der er resistente = modstandsdygtige overfor alle antibiotika i penicillinfamilien
Optimering af mikrobiologisk betjening af praksis i Region Hovedstaden
 Optimering af mikrobiologisk betjening af praksis i Region Hovedstaden Ledende overlæge, PhD, Dr.med Hvidovre Hospital 1 Den nationale handlingsplan (fra 2017) for antibiotika til mennesker Forbruget af
Optimering af mikrobiologisk betjening af praksis i Region Hovedstaden Ledende overlæge, PhD, Dr.med Hvidovre Hospital 1 Den nationale handlingsplan (fra 2017) for antibiotika til mennesker Forbruget af
MIKAP REGION NORDJYLLAND
 MIKAP REGION NORDJYLLAND KURSUS KATALOG FORÅR 2012 KURSUS A: MIKROSKOPI AF URIN OG VAGINAL SEKRET FOR BEGYNDERE Målgruppe: Personale, der skal varetage mikroskopi af urin og vaginal sekret i praksis. Kurset
MIKAP REGION NORDJYLLAND KURSUS KATALOG FORÅR 2012 KURSUS A: MIKROSKOPI AF URIN OG VAGINAL SEKRET FOR BEGYNDERE Målgruppe: Personale, der skal varetage mikroskopi af urin og vaginal sekret i praksis. Kurset
TILSIGTET BRUG BBL MGIT BBL MGIT
 BBL MGIT Mycobacteria Growth Indicator Tube 7 ml Tilsat BACTEC MGIT Growth Supplement (vækstsupplement), BBL MGIT PANTA Antibiotic Mixture (antibiotisk blanding) L000180JAA 2007/06 Dansk TILSIGTET BRUG
BBL MGIT Mycobacteria Growth Indicator Tube 7 ml Tilsat BACTEC MGIT Growth Supplement (vækstsupplement), BBL MGIT PANTA Antibiotic Mixture (antibiotisk blanding) L000180JAA 2007/06 Dansk TILSIGTET BRUG
Udtagning af prøver og forsendelse ved pyodermi, enteritis, urinvejsinfektioner og sepsis
 Udtagning af prøver og forsendelse ved pyodermi, enteritis, urinvejsinfektioner og sepsis 1. Prøvetagning ved pyodermi... 2 1.1. Hvornår...2 1.2. Hvilke læsioner udtages prøver fra...2 1.3. Hvordan udtages
Udtagning af prøver og forsendelse ved pyodermi, enteritis, urinvejsinfektioner og sepsis 1. Prøvetagning ved pyodermi... 2 1.1. Hvornår...2 1.2. Hvilke læsioner udtages prøver fra...2 1.3. Hvordan udtages
Gravide og råmælksoste. Susan Rønholt Hansen / Claus Heggum
 Gravide og råmælksoste Susan Rønholt Hansen / Claus Heggum Flowdiagram for ostefremstilling Opvarmning af mælk til 32gr Syrevækker og løbe Modning Opvarmning til 50gr Lagesaltning Afkøling og valleaftapning
Gravide og råmælksoste Susan Rønholt Hansen / Claus Heggum Flowdiagram for ostefremstilling Opvarmning af mælk til 32gr Syrevækker og løbe Modning Opvarmning til 50gr Lagesaltning Afkøling og valleaftapning
Uddannelsesprogram for introduktionsstilling i specialet klinisk mikrobiologi
 Uddannelsesprogram for introduktionsstilling i specialet klinisk mikrobiologi Klinisk Mikrobiologisk Afdeling, Aalborg Sygehus Århus Universitetshospital 1. INDLEDNING Introduktionsuddannelsen i klinisk
Uddannelsesprogram for introduktionsstilling i specialet klinisk mikrobiologi Klinisk Mikrobiologisk Afdeling, Aalborg Sygehus Århus Universitetshospital 1. INDLEDNING Introduktionsuddannelsen i klinisk
Ringtesten for identifikation og resistensbestemmelse af mastitispatogener 2007
 Ringtesten for identifikation og resistensbestemmelse af mastitispatogener 2007 Ringtesten for identifikation og resistensbestemmelse af mastitispatogener 2007 Rene S. Hendriksen Frank M. Aarestrup Kaspar
Ringtesten for identifikation og resistensbestemmelse af mastitispatogener 2007 Ringtesten for identifikation og resistensbestemmelse af mastitispatogener 2007 Rene S. Hendriksen Frank M. Aarestrup Kaspar
Tidlig Graviditetstest Strimmel
 DK Tidlig Graviditetstest Strimmel Brugsanvisning Beregnet til hjemmebrug. Version 1.0 DK 17012017 Cat.No. W1-S 10mIU Babyplan Tidlig Graviditetstest er en hurtig graviditetstest som du let kan udføre
DK Tidlig Graviditetstest Strimmel Brugsanvisning Beregnet til hjemmebrug. Version 1.0 DK 17012017 Cat.No. W1-S 10mIU Babyplan Tidlig Graviditetstest er en hurtig graviditetstest som du let kan udføre
Forebyggelse af tidligt indsættende neonatal GBS sygdom
 Titel: Forfattergruppe: Fagligt ansvarlige DPS-udvalg: Håndtering af børn i risiko for udvikling af neonatal GBS sygdom Signe Bødker Thim, Stine Yde, Rikke Helmig, Ole Pryds, Tine Brink Henriksen Neonatologi
Titel: Forfattergruppe: Fagligt ansvarlige DPS-udvalg: Håndtering af børn i risiko for udvikling af neonatal GBS sygdom Signe Bødker Thim, Stine Yde, Rikke Helmig, Ole Pryds, Tine Brink Henriksen Neonatologi
Validering og brug af Fecal Swab i routinen med WASP
 Validering og brug af Fecal Swab i routinen med WASP Alice Friis-Møller, MD, Consultant microbiologist Gitta Stendal, Louise Barry Christensen Department of Clinical Microbiology, Hvidovre Hospital, Denmark
Validering og brug af Fecal Swab i routinen med WASP Alice Friis-Møller, MD, Consultant microbiologist Gitta Stendal, Louise Barry Christensen Department of Clinical Microbiology, Hvidovre Hospital, Denmark
Metodeafprøvning. Bestemmelse af coliforme bakterier og E. coli i spildevand. Naturstyrelsens Referencelaboratorium. Miljøanalyser
 Metodeafprøvning Bestemmelse af coliforme bakterier og E. coli i spildevand Naturstyrelsens Referencelaboratorium for Mikrobiologiske Miljøanalyser Titel: Metodeafprøvning, bestemmelse af coliforme bakterier
Metodeafprøvning Bestemmelse af coliforme bakterier og E. coli i spildevand Naturstyrelsens Referencelaboratorium for Mikrobiologiske Miljøanalyser Titel: Metodeafprøvning, bestemmelse af coliforme bakterier
Bakterier struktur og funktion
 Bakterier struktur og funktion Uffe B. Skov Sørensen Dias 1 Disposition Forskellen mellem en bakterie og vore egne celler Hvad er en bakterie? Dyrkning og farvning af bakterier Inddeling af bakterier (taksonomi)
Bakterier struktur og funktion Uffe B. Skov Sørensen Dias 1 Disposition Forskellen mellem en bakterie og vore egne celler Hvad er en bakterie? Dyrkning og farvning af bakterier Inddeling af bakterier (taksonomi)
Dtec Streptokokk A testkort
 SKUP SKandinavisk utprøvning af laboratorieudstyr til Almen Praksis Dtec Streptokokk A testkort Strep A test afprøvning i hospitals laboratorium rekvireret af Dtec AS, Norge Afprøvning i regi af af SKUP
SKUP SKandinavisk utprøvning af laboratorieudstyr til Almen Praksis Dtec Streptokokk A testkort Strep A test afprøvning i hospitals laboratorium rekvireret af Dtec AS, Norge Afprøvning i regi af af SKUP
Eksogene håndinfektioner:
 Eksogene håndinfektioner: infektion som komplikation til dyre- og menneskebid Henrik C. Schønheyder Klinisk mikrobiologisk afdeling Aalborg Sygehus - Århus Universitetshospital Mange muligheder for kontakt
Eksogene håndinfektioner: infektion som komplikation til dyre- og menneskebid Henrik C. Schønheyder Klinisk mikrobiologisk afdeling Aalborg Sygehus - Århus Universitetshospital Mange muligheder for kontakt
Ringtesten for identifikation og resistensbestemmelse af mastitispatogener
 Ringtesten for identifikation og resistensbestemmelse af mastitispatogener - Uddrag af Mastitisringtest rapporten 21*) Forsker Rene S. Hendriksen 1 Levnedsmiddelingeniør Susanne Karlsmose 1 Laborant Jacob
Ringtesten for identifikation og resistensbestemmelse af mastitispatogener - Uddrag af Mastitisringtest rapporten 21*) Forsker Rene S. Hendriksen 1 Levnedsmiddelingeniør Susanne Karlsmose 1 Laborant Jacob
BD Mueller Hinton II Agar BD Mueller Hinton II Agar 150 mm BD Mueller Hinton II Agar, Square
 BRUGSANVISNING PLADEMEDIER KLAR TIL BRUG PA-254032.08 Rev.: Februar 2017 BD Mueller Hinton II Agar BD Mueller Hinton II Agar 150 mm BD Mueller Hinton II Agar, Square TILSIGTET BRUG BD Mueller Hinton II
BRUGSANVISNING PLADEMEDIER KLAR TIL BRUG PA-254032.08 Rev.: Februar 2017 BD Mueller Hinton II Agar BD Mueller Hinton II Agar 150 mm BD Mueller Hinton II Agar, Square TILSIGTET BRUG BD Mueller Hinton II
Biokonservering af koldrøget laks
 Af Lilian Nilsson og Lone Gram Afdeling for Fiskeindustriel Forskning, Danmarks Fiskeriundersøgelser Biokonservering af koldrøget laks - hvordan man forhindrer vækst af Listeria i fiskeprodukter er en
Af Lilian Nilsson og Lone Gram Afdeling for Fiskeindustriel Forskning, Danmarks Fiskeriundersøgelser Biokonservering af koldrøget laks - hvordan man forhindrer vækst af Listeria i fiskeprodukter er en
Collection and Transport System
 B Liquid Amies Elution Swab (ESwab) Collection and Transport System 54(02) 2014-08 Dansk 0086 TILSIGTET BRUG BD Liquid Amies Elution Swab (ESwab) Collection and Transport System (indsamlings- og transportsystem)
B Liquid Amies Elution Swab (ESwab) Collection and Transport System 54(02) 2014-08 Dansk 0086 TILSIGTET BRUG BD Liquid Amies Elution Swab (ESwab) Collection and Transport System (indsamlings- og transportsystem)
BD Sensi-Disc Susceptibility Test Discs
 BRUGSANVISNING BD SENSI-DISCS SD-BD.01 Rev.: Maj 2005 BD Sensi-Disc Susceptibility Test Discs TILSIGTET BRUG Sensi-Disc susceptibility test discs (Sensi-Disc disks til følsomhedstest) anvendes til semikvantitativ
BRUGSANVISNING BD SENSI-DISCS SD-BD.01 Rev.: Maj 2005 BD Sensi-Disc Susceptibility Test Discs TILSIGTET BRUG Sensi-Disc susceptibility test discs (Sensi-Disc disks til følsomhedstest) anvendes til semikvantitativ
Fødevarestyrelsen. Nye regler for spirevirksomheder. 25.07.2013 J.nr. 2013-28-2301-01326/NLN/CAM
 Fødevarestyrelsen FØDEVARESTYRELSEN 25.07.2013 J.nr. 2013-28-2301-01326/NLN/CAM Nye regler for spirevirksomheder 1 Indledning Europa Kommissionen har i marts 2013 vedtaget fire nye forordninger, som skal
Fødevarestyrelsen FØDEVARESTYRELSEN 25.07.2013 J.nr. 2013-28-2301-01326/NLN/CAM Nye regler for spirevirksomheder 1 Indledning Europa Kommissionen har i marts 2013 vedtaget fire nye forordninger, som skal
